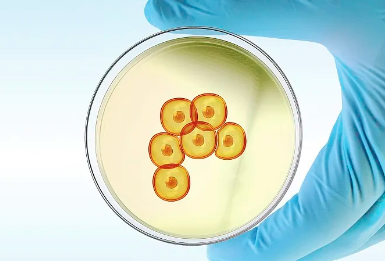
image.png

蘋果干細(xì)胞有什么作用,蘋果干細(xì)胞的使用步驟
2024-09-12 10:48:19 來源: 小編 咨詢醫(yī)生
蘋果干細(xì)胞提取自瑞士一種名為“烏爾斯特蘋果”的特殊蘋果品種,這種干細(xì)胞因其出色的延緩衰老效果而受到廣泛關(guān)注。蘋果干細(xì)胞主要具有以下幾個作用:
一、蘋果干細(xì)胞的作用
1.抗衰老作用
蘋果干細(xì)胞含有豐富的生物活性成分,能夠有效延緩細(xì)胞老化。研究表明,這些干細(xì)胞所含的活性物質(zhì)可以促進(jìn)皮膚細(xì)胞的再生,增強(qiáng)膠原蛋白的合成,從而提升皮膚的彈性和緊致度。
2.修復(fù)肌膚
蘋果干細(xì)胞具有強(qiáng)大的再生能力,可以修復(fù)皮膚受損,改善膚色不均及色素沉著,有助于讓肌膚恢復(fù)健康的光澤。
3.抗氧化作用
富含抗氧化成分的蘋果干細(xì)胞能夠中和自由基,減少因環(huán)境污染與紫外線照射造成的氧化損傷,保護(hù)皮膚免受外界侵害。
4.刺激毛發(fā)生長
研究也顯示,蘋果干細(xì)胞在促進(jìn)毛囊再生、改善脫發(fā)問題方面表現(xiàn)出積極效果,能夠刺激毛發(fā)生長,增強(qiáng)發(fā)質(zhì)。
二、蘋果干細(xì)胞的使用步驟
在護(hù)膚和美容領(lǐng)域,蘋果干細(xì)胞的使用流程相對簡單,具體步驟如下:
1.清潔皮膚
使用溫和的潔面產(chǎn)品徹底清潔面部,確保去除多余的油脂和污垢,為后續(xù)護(hù)膚步驟做好準(zhǔn)備。
2.使用蘋果干細(xì)胞精華
取適量蘋果干細(xì)胞精華,輕輕點涂于面部及頸部,隨后用手掌輕輕拍打,使精華液更好地滲透入皮膚中。
3.按摩吸收
輕輕按摩面部,可以促進(jìn)血液循環(huán),增強(qiáng)蘋果干細(xì)胞成分的吸收效果。建議按摩時間控制在3-5分鐘。
4.補水鎖水
在蘋果干細(xì)胞精華吸收后,使用適合自己膚質(zhì)的補水面霜或乳液,鎖住水分,增強(qiáng)皮膚的滋潤感。
5.定期使用
為了達(dá)到最佳效果,建議每周進(jìn)行3-4次蘋果干細(xì)胞護(hù)理,并結(jié)合健康的生活方式和飲食習(xí)慣,以整體提升皮膚狀態(tài)。
三、總結(jié)
蘋果干細(xì)胞因其獨特的護(hù)膚效果而備受推崇,不僅能夠有效抗老、修復(fù)肌膚,還具有抗氧化、促進(jìn)發(fā)育的功能。采用正確的使用步驟,能夠最大程度地發(fā)揮其功效,使皮膚達(dá)到更年輕、更健康的狀態(tài)。希望本文能對您了解蘋果干細(xì)胞的作用及使用方法有所幫助。
- 2024-10-07干細(xì)胞回輸?shù)淖饔糜心男?,具體作用機(jī)理是怎樣的
- 2024-09-14全球干細(xì)胞十大權(quán)威公司排名
- 2024-10-21博鰲醫(yī)院在干細(xì)胞治療方面有何優(yōu)勢?
- 2024-10-30造血干細(xì)胞續(xù)命療法有哪些優(yōu)勢與局限?
- 2024-09-14干細(xì)胞療法疼不疼,干細(xì)胞注射后真實感覺
- 2024-11-18腦炎干細(xì)胞療法價格貴嗎,治療效果如何
- 2024-08-27南京儲存干細(xì)胞的價格,不同類型干細(xì)胞儲存費用
- 2024-09-12上海干細(xì)胞注射機(jī)構(gòu),上海細(xì)胞機(jī)構(gòu)名單公示
- 2024-09-01骨髓干細(xì)胞移植需要配型嗎,移植前的配型要求
- 2024-09-01造血干細(xì)胞移植適應(yīng)癥及禁忌癥
- 2024-09-02干細(xì)胞技術(shù)用于生殖的原理效果
- 2024-10-07日照干細(xì)胞捐贈機(jī)構(gòu)如何選擇?哪些因素需特別注意?
- 2024-10-11推銷干細(xì)胞產(chǎn)品有效方法有哪些?如何提升信任度?
- 2024-08-22造血干細(xì)胞移植并發(fā)癥有哪些,附處理方法
- 2024-07-21捐造血干細(xì)胞,捐造血干細(xì)胞的全過程
- 2024-10-04東陽免疫干細(xì)胞存儲哪家強(qiáng)?如何選擇正規(guī)機(jī)構(gòu)?
- 2024-09-27艾樂貝拉國際細(xì)胞中心可靠嗎
- 2024-10-10持續(xù)輸干細(xì)胞抗衰老有效嗎?揭秘抗衰老新趨勢
